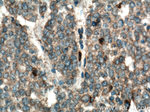
CA4 Antibody in Immunohistochemistry (Paraffin) (IHC (P))

Search
Proteintech
CA4 Polyclonal Antibody
{{$productOrderCtrl.translations['antibody.pdp.commerceCard.promotion.promotions']}}
{{$productOrderCtrl.translations['antibody.pdp.commerceCard.promotion.viewpromo']}}
{{$productOrderCtrl.translations['antibody.pdp.commerceCard.promotion.promocode']}}: {{promo.promoCode}} {{promo.promoTitle}} {{promo.promoDescription}}. {{$productOrderCtrl.translations['antibody.pdp.commerceCard.promotion.learnmore']}}
产品信息
13931-1-AP
种属反应
宿主/亚型
分类
类型
抗原
偶联物
形式
浓度
规格
纯化类型
保存液
内含物
保存条件
运输条件
产品详细信息
Immunogen sequence: ASAESHWCY EVQAESSNYP CLVPVKWGGN CQKDRQSPIN IVTTKAKVDK KLGRFFFSGY DKKQTWTVQN NGHSVMMLLE NKASISGGGL PAPYQAKQLH LHWSDLPYKG SEHSLDGEHF AMEMHIVHEK EKGTSRNVKE AQDPEDEIAV LAFLVEAGTQ VNEGFQPLVE ALSNIPKPEM STTMAESSLL DLLPKEEKLR HYFRYLGSLT TPTCDEKVVW TVFREPIQLH REQILAFSQK LYYDKEQTVS MKDNVRPLQQ LGQRTVIKS (17-284 aa encoded by BC057792)
靶标信息
Carbonic anhydrases are a large family of zinc metalloenzymes that catalyze the reversible hydration of carbon dioxide. They participate in a variety of biological processes, including respiration, calcification, acid-base balance, bone resorption, and the formation of aqueous humor, cerebrospinal fluid, saliva, and gastric acid. They show extensive diversity in tissue distribution and in their subcellular localization. This gene encodes a glycosylphosphatidyl-inositol-anchored membrane isozyme expressed on the luminal surfaces of pulmonary capillaries and proximal renal tubules. Its exact function is not known, however, it may have a role in inherited renal abnormalities of bicarbonate transport.
仅用于科研。不用于诊断过程。未经明确授权不得转售。
生物信息学
蛋白别名: CA IV; CA-IV; CA4; Carbonate dehydratase IV; Carbonic anhydrase 4; Carbonic anhydrase IV; carbonic dehydratase IV; unnamed protein product
基因别名: AW456718; CA4; CAIV; Car4; RP17
UniProt ID: (Human) P22748, (Mouse) Q64444, (Rat) P48284
Entrez Gene ID: (Human) 762, (Mouse) 12351, (Rat) 29242